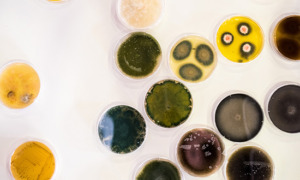

2025.12.04
- コラム
カビ除去システム【Goldmorr】
Goldmorr(カビ除去クリーニング)
まとめ
すべてのカビとカビ胞子を住居から取り除くことは不可能です。しかし、乾燥状態に保つことでカビの繁殖を抑制することは可能です。
クリーンな環境で生活をすることは衛生的にもとても重要です。
お掃除classicはGoldmorrを施工出来るマスターテクニシャンのライセンスを取得しております。
須坂市や近隣市町村だけでなく、長野県内全域、近隣県でも可能であればお伺いいたします。
ぜひお掃除classicのクリーニングサービスをご利用ください。
各お問い合わせよりお気軽にご相談ください。
お問い合わせ先